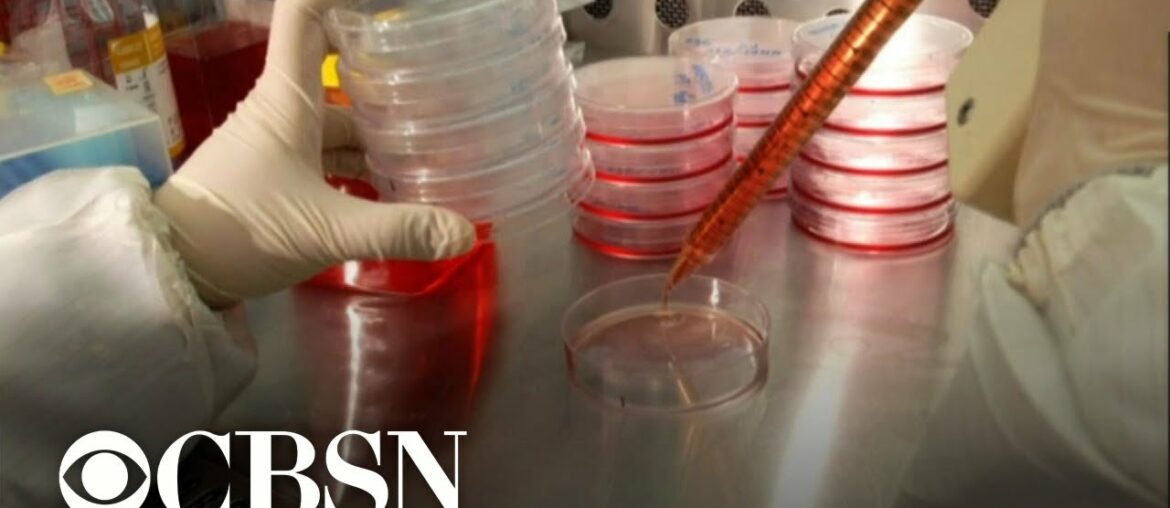
Study: Immune system may never forget mild COVID-19 infection

Junior Fellow Harvard University asal Indonesia pertama—Novalia Pishesha—membahas proses panjang di balik dua temuan rekayasa sel darah merah yang dipatenkannya, bagaimana Ia bisa terlibat dalam riset milik tokoh pencetak peraih Nobel, serta bagaimana perempuan dapat lebih berperan dalam bidang MIPA,…